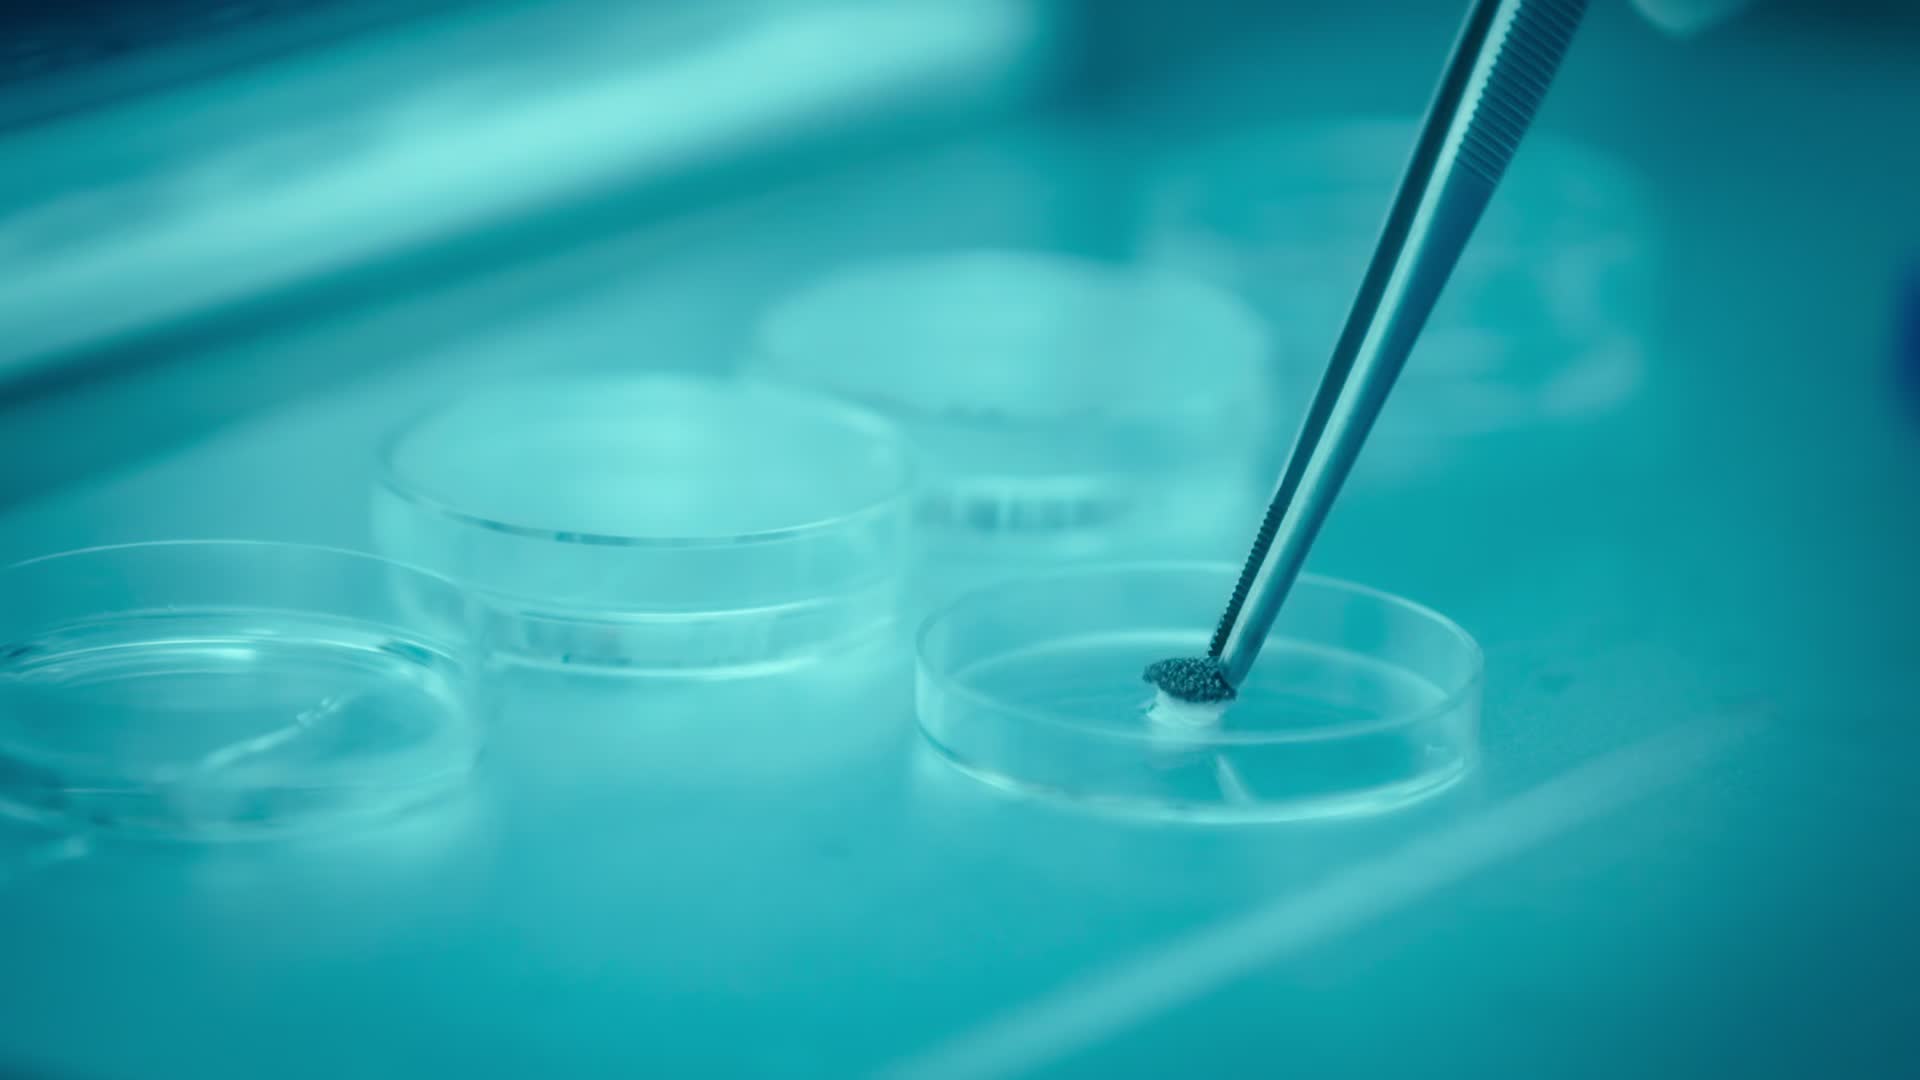

Page One Inside The New York Times 2011 1080p AMZN WEB-DL H264-GPRS
Download Torrent
Opens in your torrent client (e.g. qBittorrent)
Health
Fair1/0
Info Hash6981f2b16d77afaa83151a5ee6720711147217c3
Peers Updated2 days ago (2026-06-26 18:20:40)

Page One: Inside the New York Times
65 votes
This year, the biggest story is their own.
Unprecedented access to the New York Times newsroom yields a complex view of the transformation of a media landscape fraught with both peril and opportunity.
Director: Andrew Rossi
Cast: David Carr, Brian Stelter, Bruce Headlam, Richard Perez-Pena, Sarah Ellison
Cast: David Carr, Brian Stelter, Bruce Headlam, Richard Perez-Pena, Sarah Ellison
Description
~~~~~~~~~~~~~~~~~~~~~~~~~~~~~~~~~~~~~~~~~~~~~~~~~
UIndex.org - Your Gateway to the Latest Torrents!
Try: https://uindex.org
~~~~~~~~~~~~~~~~~~~~~~~~~~~~~~~~~~~~~~~~~~~~~~~~~
.Title : Page One Inside The New York Times 2011 1080p AMZN WEB-DL H264-GPRS
File Size : 2.16 GB
Duration : 1 h 25 min
Format : Matroska
Video:
Codec : HEVC
Resolution : 1 920 pixels x 1 080 pixels
Frame Rate : 25.000 FPS
Bitrate : 2 118 kb/s
Overall Bitrate : 3 598 kb/s
Audio:
Codec : E-AC-3
Bitrate : 640 kb/s
Language(s) : English, Korean
Subtitle(s) : Arabic, Chinese, Chinese, Croatian, Czech, Danish, Dutch, English, English, English, English, English, Finnish, French, Filipino, German, Greek, Hebrew, Hungarian, Indonesian, Italian, Japanese, Korean, Korean, Korean, Malay, Norwegian Bokmal, Polish, Portuguese, Portuguese, Romanian, Russian, Spanish, Spanish, Swedish, Thai, Turkish, Ukrainian, Vietnamese
Screenshots:



UIndex.org - Your Gateway to the Latest Torrents!
Try: https://uindex.org
~~~~~~~~~~~~~~~~~~~~~~~~~~~~~~~~~~~~~~~~~~~~~~~~~
.Title : Page One Inside The New York Times 2011 1080p AMZN WEB-DL H264-GPRS
File Size : 2.16 GB
Duration : 1 h 25 min
Format : Matroska
Video:
Codec : HEVC
Resolution : 1 920 pixels x 1 080 pixels
Frame Rate : 25.000 FPS
Bitrate : 2 118 kb/s
Overall Bitrate : 3 598 kb/s
Audio:
Codec : E-AC-3
Bitrate : 640 kb/s
Language(s) : English, Korean
Subtitle(s) : Arabic, Chinese, Chinese, Croatian, Czech, Danish, Dutch, English, English, English, English, English, Finnish, French, Filipino, German, Greek, Hebrew, Hungarian, Indonesian, Italian, Japanese, Korean, Korean, Korean, Malay, Norwegian Bokmal, Polish, Portuguese, Portuguese, Romanian, Russian, Spanish, Spanish, Swedish, Thai, Turkish, Ukrainian, Vietnamese
Screenshots: